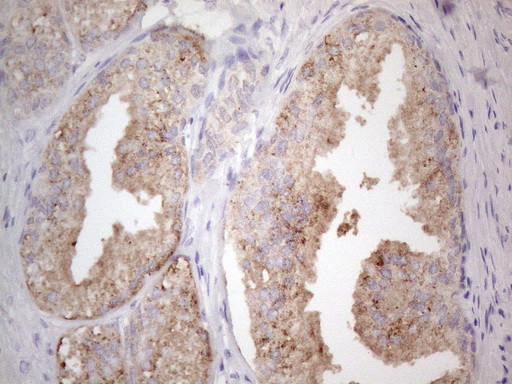
JAK2 Antibody in Immunohistochemistry (Paraffin) (IHC (P))

Search
OriGene
JAK2 Monoclonal Antibody (OTI7D12), TrueMAB™
{{$productOrderCtrl.translations['antibody.pdp.commerceCard.promotion.promotions']}}
{{$productOrderCtrl.translations['antibody.pdp.commerceCard.promotion.viewpromo']}}
{{$productOrderCtrl.translations['antibody.pdp.commerceCard.promotion.promocode']}}: {{promo.promoCode}} {{promo.promoTitle}} {{promo.promoDescription}}. {{$productOrderCtrl.translations['antibody.pdp.commerceCard.promotion.learnmore']}}
产品信息
TA806794
种属反应
宿主/亚型
分类
类型
克隆号
抗原
偶联物
形式
浓度
纯化类型
保存液
内含物
保存条件
运输条件
靶标信息
Janus kinase 2 (JAK2) is a protein tyrosine kinase involved in a specific subset of cytokine receptor signaling pathways and is mutated in polycythemia vera. This kinase contains the catalytic domain (JH1) of JAK2. The activation of JAKs can lead to the phosphorylation of STAT (signal transducers and activatiors of transcription) proteins, which dimerize and translocate to the nucleus. Once translocated to the nucleus, the STAT proteins can modify transcription of numerous genes, including interferon-stimulated genes. JAK2 is required for the IFN gamma-receptor complex initiation and JAK1 functions as an amplifier. Some studies have suggested that the role of JAK2 might be performed by Tyk2 and JAK3, if they were positioned correctly within the IFN gamma-receptor complex. Mutations affecting JAK2 can cause Budd-Chiari syndrome, Polycythemia vera, Thrombocythemia 3, myelofibrosis, or Acute myelogenous leukemia.
仅用于科研。不用于诊断过程。未经明确授权不得转售。
篇参考文献 (0)
生物信息学
蛋白别名: EC 2.7.10.2; JAK 2; JAK-2; Janus kinase 2; Janus kinase 2 (a protein tyrosine kinase); JTK 10; kinase Jak2; Tyrosine-protein kinase JAK2
基因别名: JAK2; JTK10; THCYT3
UniProt ID: (Human) O60674
Entrez Gene ID: (Human) 3717